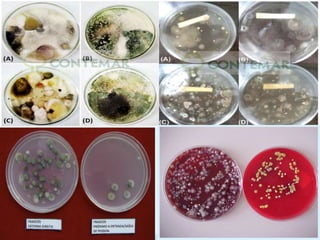

Este documento discute microorganismos e saúde em três frases:
Aborda como fungos, bactérias e vírus podem afetar positiva ou negativamente a saúde humana, com exemplos de doenças causadas e usos médicos e industriais. Também propõe atividades experimentais e discussões para estudar esses temas ao longo de 6 aulas.